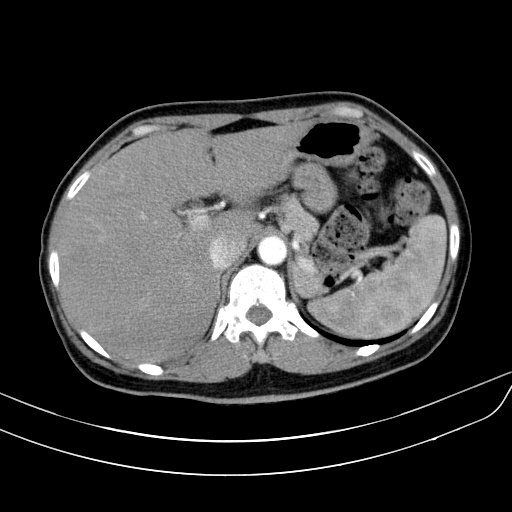
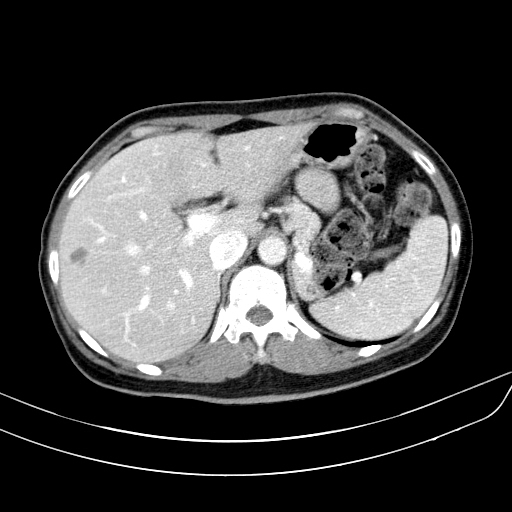

상복부통증을 주소로 내원한 50세 남자환자의 복부CT영상입니다. 담낭벽이 두꺼워져 있어 담낭염이 의심되어 치료하였으며, 조영증강 전 및 조영증강 후 영상에서 간 내에 별다른 국소병변은 보이지 않습니다.


2개월 후 담낭염의 호전여부를 확인하기 위해 간초음파를 시행했습니다. 담낭벽비후는 깨끗하게 호전되었는데, 간우엽에 고에코음영의 종괴가 발견되었습니다. 이전 복부CT영상을 다시 확인해도 전혀 보이지 않는 종괴였으며, 크기가 1.7센티미터로 크기가 작아서 확인이 안될 상황은 전혀 아니었습니다.
종괴는 균일한 고에코음영을 보였지만, 후방에코강조(posterior acoustic enhancement)가 보이지 않았고 모양도 각이 지고 약간 불규칙한 형태를 보였기 때문에 간혈관종의 가능성은 떨어졌기에 추가적인 확인을 위해 간의 다이나믹 조영증강 영상을 추가로 시행했습니다.

왼쪽 영상이 arterial phase, 오른쪽 위는 portal phase, 마지막으로 오른쪽 아래 영상이 delayed phase 영상입니다. arterial phase에서도 어느정도 조영증강이 되어 주변의 간실질과 비슷한 감쇄도를 보이고 있습니다. 다만, portal 및 delayed phase에서 조영제가 완전히 빠져나가 뚜렷한 저음영으로 보이는 wash-out 양상을 보이지 않고 조영제가 병변 안에 어느정도 머물러 있습니다.
이러한 양상으로 볼 때 간세포암보다는 이형성 결절(dysplastic nodule)일 가능성이 커 보이므로 초음파영상을 통한 추적관찰을 하게 된 케이스입니다.
간에서 발생하는 악성 종양의 대부분을 차지하는 간암은 대게 전형적인 wash-out 양상을 보이기 때문에 굳이 다이나믹 CT를 촬영하지 않아도 위의 증례처럼 병변을 놓칠만큼 애매하게 보이는 경우는 드뭅니다. 그러므로 간암의 발견과 진단 목적으로 복부CT는 매우 유용한 영상검사입니다.
다만 우리가 항상 주의해야 하는 건 위 증례에서처럼 복부 CT 상 간 내에 국소병변이 보이지 않는다고 해서 실제로 아무런 병변이 없다고 확신하면 안된다는 것입니다. 이번 증례에서처럼 1센티미터가 넘는 결절이 CT영상에서는 전혀 보이지 않은채로 숨겨져있을 수가 있기 때문입니다.